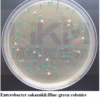

Продукция, которой доверяют лидеры рынка
Ассортимент HuanKai включает более 2000 наименований. Мы гордимся тем, что представляем продукцию, которой доверяют такие мировые лидеры, как PepsiCo, Danone, The Coca-Cola Company, Amway, Bayer AG и многие другие.
Наши решения
Мы предлагаем комплексные решения для лабораторных исследований, охватывающие ключевые направления:
Классическое микробиологическое тестирование: Реагенты и расходные материалы, включая культуральные среды от ведущего бренда HKM.
Экспресс-тесты: Современные решения от бренда BHK (HuanKai Biology) для быстрой идентификации микроорганизмов, производства вакцин и генной инженерии.
Оборудование и расходные материалы: Лабораторные приборы, а также расходники для микробиологических исследований, включая решения для анализа воды и реагенты от бренда CHK.
Моющие и дезинфицирующие средства: Эффективные и экологически безопасные продукты для лабораторий и производственных линий, также разработанные под брендом
Мы гордимся тем, что предоставляем продукцию, которая отвечает самым высоким требованиям качества и надежности.
| Код | Название продукта | Спецификация | Предполагаемое применение |
| 021010P1 | Агар с бенгальским розовым | 250 г | Для подсчета, выделения и культивирования плесневых грибов и дрожжей. |
| 021096P1 | Бульон Сабуро с декстрозой | 250 г | Для культивирования дрожжей и плесневых грибов. |
| 021098P1 | Агар Сабуро с декстрозой | 250 г | Для выделения и идентификации Candida. |
| 021099P1 | Агар Сабуро с декстрозой | 250 г | Для культивирования и общего подсчета дрожжей и плесневых грибов. |
| 022011P1 | Питательный бульон | 250 г | Для общего культивирования, оживления и обогащения бактерий. |
| 022021P1 | Питательный агар | 250 г | Для культивирования, подсчета и сохранения неприхотливых бактерий. |
| 022029P1 | Агар R2A | 250 г | Для определения общего количества бактерий в воде. |
| 022039P1 | Бульон МакКонки | 250 г | Для селективного обогащения колиформных организмов. |
| 022040P1 | Желчно-лактозная среда | 250 г | Для многопробирочных ферментационных тестов на колиформы, фекальные колиформы и E. coli. |
| 022060P1 | Агар с Эозином и Метиленовым синим | 250 г | Для выделения и дифференциации грамотрицательных кишечных палочек, особенно колиформ и фекальных колиформ. |
| 022070P1 | Агар для чашечного посева | 250 г | Для определения аэробного бактериального счета. |
| 022116P1 | Физиологический раствор pH 7.0 с хлоридом натрия и пептоном | 250 г | Для разведения образцов лекарственных средств и биологических продуктов. |
| 023130P1 | Буферная пептонная вода | 250 г | Для предварительного обогащения Salmonella spp. и Enterobacter sakazakii в пищевых продуктах. |
| 022161P1 | Бульон для обогащения энтеробактерий | 250 г | Для культивирования и селективного обогащения энтеробактерий. |
| 022170P1 | Желчно-солевая лактозная среда | 250 г | Для обогащения Escherichia coli и Pseudomonas aeruginosa. |
| 022210P1 | Триптонный бульон с лаурилсульфатом | 250 г | Для обнаружения колиформных бактерий и фекальных колиформ методом многопробирочной ферментации. |
| 022200P1 | Лактозный пептонный бульон | 250 г | Для обнаружения колиформных бактерий методом многопробирочной ферментации или мембранной фильтрации в воде. |
| 022220P1 | Бульон с Бриллиантовым Зеленым и Желчью | 250 г | Для обнаружения или подтверждения присутствия представителей группы coli-aerogenes. |
| 022221P1 | Агар с фиолетовым красным и желчью | 250 г | Для подсчета колоний колиформ в воде или пищевых продуктах. |
| 022230P1 | EC-бульон | 250 г | Для выделения E.coli и других колиформ. |
| 023022P1 | Среда Раппапорта-Вассилиадиса | 250 г | Для селективного обогащения Salmonella spp. в пищевых продуктах и образцах окружающей среды. |
| 023040P1 | Бульон с селенитом и цистином | 250 г | Для селективного обогащения Salmonella spp. |
| 023070P1 | Энтерогемолитический агар | 250 г | Для селективного выделения энтеропатогенных бактерий, особенно Salmonella и Shigella. |
| 024010P1 | Бульон с 7,5% хлоридом натрия | 250 г | Для селективного обогащения Staphylococcus aureus и других солеустойчивых бактерий. |
| 024022P1 | Маннит -солевой агар | 250 г | Для селективного выделения, культивирования и подсчета Staphylococcus aureus. |
| 024040P1 | Основа агара Байрда-Паркера | 250 г | Для селективного выделения и подсчета коагулазоположительных стафилококков с добавлением реагента калия теллурита и яичного желтка. |
| 024051P1 | Триптиказо-соевый бульон | 250 г | Для подготовки образцов и предварительной инкубации при микробиологическом контроле нестерильных продуктов. |
| 024053P1 | Бульон сердечно-мозговой | 250 г | Для культивирования плесневых грибов, дрожжей и бактерий, включая прихотливые микроорганизмы. |
| 024064P1 | Агар Колумбийский | 250 г | Универсальная среда, подходящая для культивирования прихотливых организмов. Охладить до 45°C и добавить 5% стерильной дефибринированной крови для Campylobacter spp. |
| 025010P1 | Щелочной пептон | 250 г | Для селективного обогащения алкалофильных бактерий, особенно видов Vibrio. |
| 025015P1 | Щелочная пептонная вода с 3% хлоридом натрия | 250 г | Для обогащения Vibrio parahaemolyticus. |
| 025020P1 | TCBS-агар | 250 г | Для селективного выделения энтеропатогенных вибрионов, особенно Vibrio cholerae и Vibrio parahaemolyticus. |
| 026040P1 | Основа бульона для обогащения листерий | 250 г | Для селективного обогащения Listeria. |
| 027043P1 | Основа цетримидного агара | 250 г | Для селективного выделения Pseudomonas. |
| 028033P1 | Жидкая тиогликолевая среда | 250 г | Для культивирования аэробных, анаэробных, микроаэрофильных микроорганизмов и для тестов на стерильность лекарственных средств, биологических продуктов или других образцов. |
| 028074P1 | Триптиказо-соевый агар | 250 г | Для выделения и культивирования неприхотливых и прихотливых микроорганизмов. |
| 029999P1 | Ксилозо-лизиновый агар с дезоксихолатом | 250 г | Для селективного выделения грамотрицательных бактерий, особенно Shigella и Salmonella. |